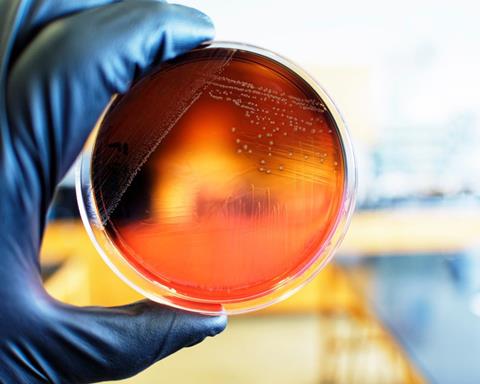
Image

Even the most robust sanitation programmes cannot fully eliminate pathogen persistence. As biofilms, harbourage sites and genomic surveillance reshape what manufacturers know about contamination risk, persistence is emerging as one of the defining tests of modern food safety.
Food safety systems have advanced significantly in recent decades. Manufacturers today operate with sophisticated sanitation chemistries, increasingly mature preventative control frameworks and diagnostic tools that continue to improve in speed and precision. Yet one issue continues to challenge food safety programmes across the sector: pathogen persistence.
Pathogen persistence has become one of the most difficult realities of modern food production – not because controls are absent, but because microorganisms have proven remarkably adept at surviving within complex systems.”
Across the industry, organisms such as Listeria monocytogenes, Salmonella and Shiga toxin-producing E. coli continue to re-emerge in processing environments, sometimes repeatedly and often without an obvious breakdown in protocol. For quality and manufacturing leaders, persistence has become one of the most difficult realities of modern food production – not because controls are absent, but because microorganisms have proven remarkably adept at surviving within complex systems.
As a result, the question is no longer simply whether sanitation and monitoring matter, but what persistence reveals about the limits of traditional approaches and the evolving science shaping pathogen control.
Persistence as a systems challenge
Recent scientific reviews and risk assessments increasingly frame persistence as a product of repeated environmental and structural conditions that allow pathogens to survive and re-enter production environments over time. In practice, this can stem from hygienic zoning weaknesses, equipment that is difficult to fully clean and dry, and microenvironments that favour microbial survival.
A 2024 European Food Safety Authority (EFSA) scientific opinion on persistence of microbiological hazards in food and feed processing environments highlights recurring contributors such as inadequate hygiene barriers, shortcomings in hygienic equipment design and gaps in sanitation effectiveness. The findings reinforce an important reality for manufacturers: persistence is shaped as much by infrastructure and system complexity as by procedural execution.
Crucially, EFSA’s assessment suggests that recurrence is not always resolved through intensifying sanitation alone. It often requires deeper understanding of where survival is occurring, and why.
The biofilm factor
Few mechanisms illustrate this more clearly than biofilm formation. Biofilms are structured microbial communities embedded in protective matrices that adhere strongly to surfaces. Within these communities, pathogens can exhibit increased tolerance to sanitisers and environmental stress, allowing them to persist in niches that routine cleaning may not fully disrupt.
Industry reporting has highlighted biofilm formation on food-contact surfaces as a growing threat, noting how microbial communities can persist despite rigorous cleaning regimes and create long-term environmental reservoirs for pathogens such as Salmonella and Listeria.
Peer-reviewed evidence underscores both the impact and the limitations of chemical interventions against these communities. A 2025 systematic review and meta-analysis examining sanitiser effects on bacterial biofilms reported an estimated mean reduction of around 2.9 log overall, with outcomes strongly influenced by sanitiser category.
This variability helps explain why reduction may not always translate into complete elimination, particularly where protected communities remain established within facility niches.
Biofilms, in this sense, represent one of the most resilient drivers of persistence, reflecting microbial adaptation under environmental stress.
Harbourage and the hidden geography of risk
Persistence is not only biological. It is also deeply structural, shaped by the hidden geography of the plant environment. Harbourage sites provide the physical context in which pathogens endure, often forming in moisture-prone or inaccessible areas such as drains, worn seals, conveyor joints, hollow rollers or framework interiors.
Over time, these microenvironments can support survival and periodic reseeding of the wider processing environment. EFSA’s persistence analysis reinforces the role of hygienic design and zoning discipline in limiting these reservoirs.
For manufacturers, recurrence patterns frequently point to the same underlying challenge. Risk often resides in the spaces that are hardest to inspect, hardest to dry and easiest to normalise within daily operations.
When persistence becomes an outbreak
The implications of persistence extend far beyond environmental positives. Outbreak and recall data provide some of the clearest illustrations of how contamination can expand into supply-chain-wide impact.
A multistate Listeria monocytogenes outbreak linked to ready-to-eat pasta meals highlights how contamination can persist and spread through complex production and distribution systems. The outbreak was traced to precooked pasta produced by California supplier Nate’s Fine Foods, with reported illnesses spanning 18 US states and resulting in six deaths.
As persistence has become harder to eliminate, detection has become equally central.”
Investigators confirmed a genetic match between pasta produced by Nate’s Fine Foods and multiple recalled finished meals. This demonstrates how whole genome sequencing (WGS) has become central to linking contamination findings with human cases and tracing persistence across interconnected supply chains.
Such investigations underscore the stakes for manufacturers operating in ready-to-eat categories, where post-process contamination pathways can have profound consequences. More broadly, EFSA reported that listeriosis accounted for the highest proportion of hospitalisations and deaths among foodborne infections in Europe in 2024, with around seven in ten cases requiring hospital care and approximately one in 12 resulting in death.
Surveillance, sequencing and rising expectations
As persistence has become harder to eliminate, detection has become equally central. WGS is now a critical tool in outbreak investigation and pathogen source attribution, improving the ability to distinguish closely related isolates and connect contamination events over time.
At a broader level, national surveillance initiatives illustrate how the food safety landscape is shifting towards data-rich pathogen intelligence. In the UK, the PATH-SAFE programme has strengthened foodborne disease surveillance through large-scale sequencing efforts, creating a more robust genomic foundation for outbreak response and long-term pathogen tracking.
In turn, persistence is increasingly being mapped through surveillance systems that reveal patterns across facilities, products and supply chains.
Emerging science and the next frontier of control
Research continues to probe new ways to disrupt persistence. One recent study has shown that certain plant-based compounds can enhance the antimicrobial effects of blue light against Listeria on salmon and reduce its biofilm-forming potential, pointing to emerging control strategies that move beyond traditional chemical sanitisers.
While such approaches remain experimental, they reflect the interdisciplinary direction of persistence research, particularly in the search for biofilm-disruptive strategies. Other studies also reinforce the need for evidence-led validation of interventions, highlighting the importance of robust monitoring and targeted control measures to reduce overall contamination risk.
Persistence as a driver of resilience-focused food safety strategy
Across research and real-world evidence, persistence emerges as one of the defining tests of modern food safety systems. Hygienic design, zoning discipline, sanitation validation, monitoring intelligence and corrective action frameworks increasingly function as integrated elements of long-term risk reduction.
EFSA’s synthesis of persistence risk factors provides a reminder that microbial control is shaped by infrastructure as well as procedure. Facilities that treat recurrence patterns as actionable intelligence are better positioned to reduce long-term risk, strengthen preventative controls and sustain operational stability.
For professionals seeking deeper practical guidance on today’s pathogen risks, detection workflows and mitigation tools, Nestlé’s upcoming webinar, Pathogen Risks in Today’s Food Supply: Practical Strategies for Manufacturing & Quality Teams, on Thursday, 19 March 2026 from 1:00PM to 2:00PM EST, will expand on these themes with real-world case studies and operational decision frameworks.


